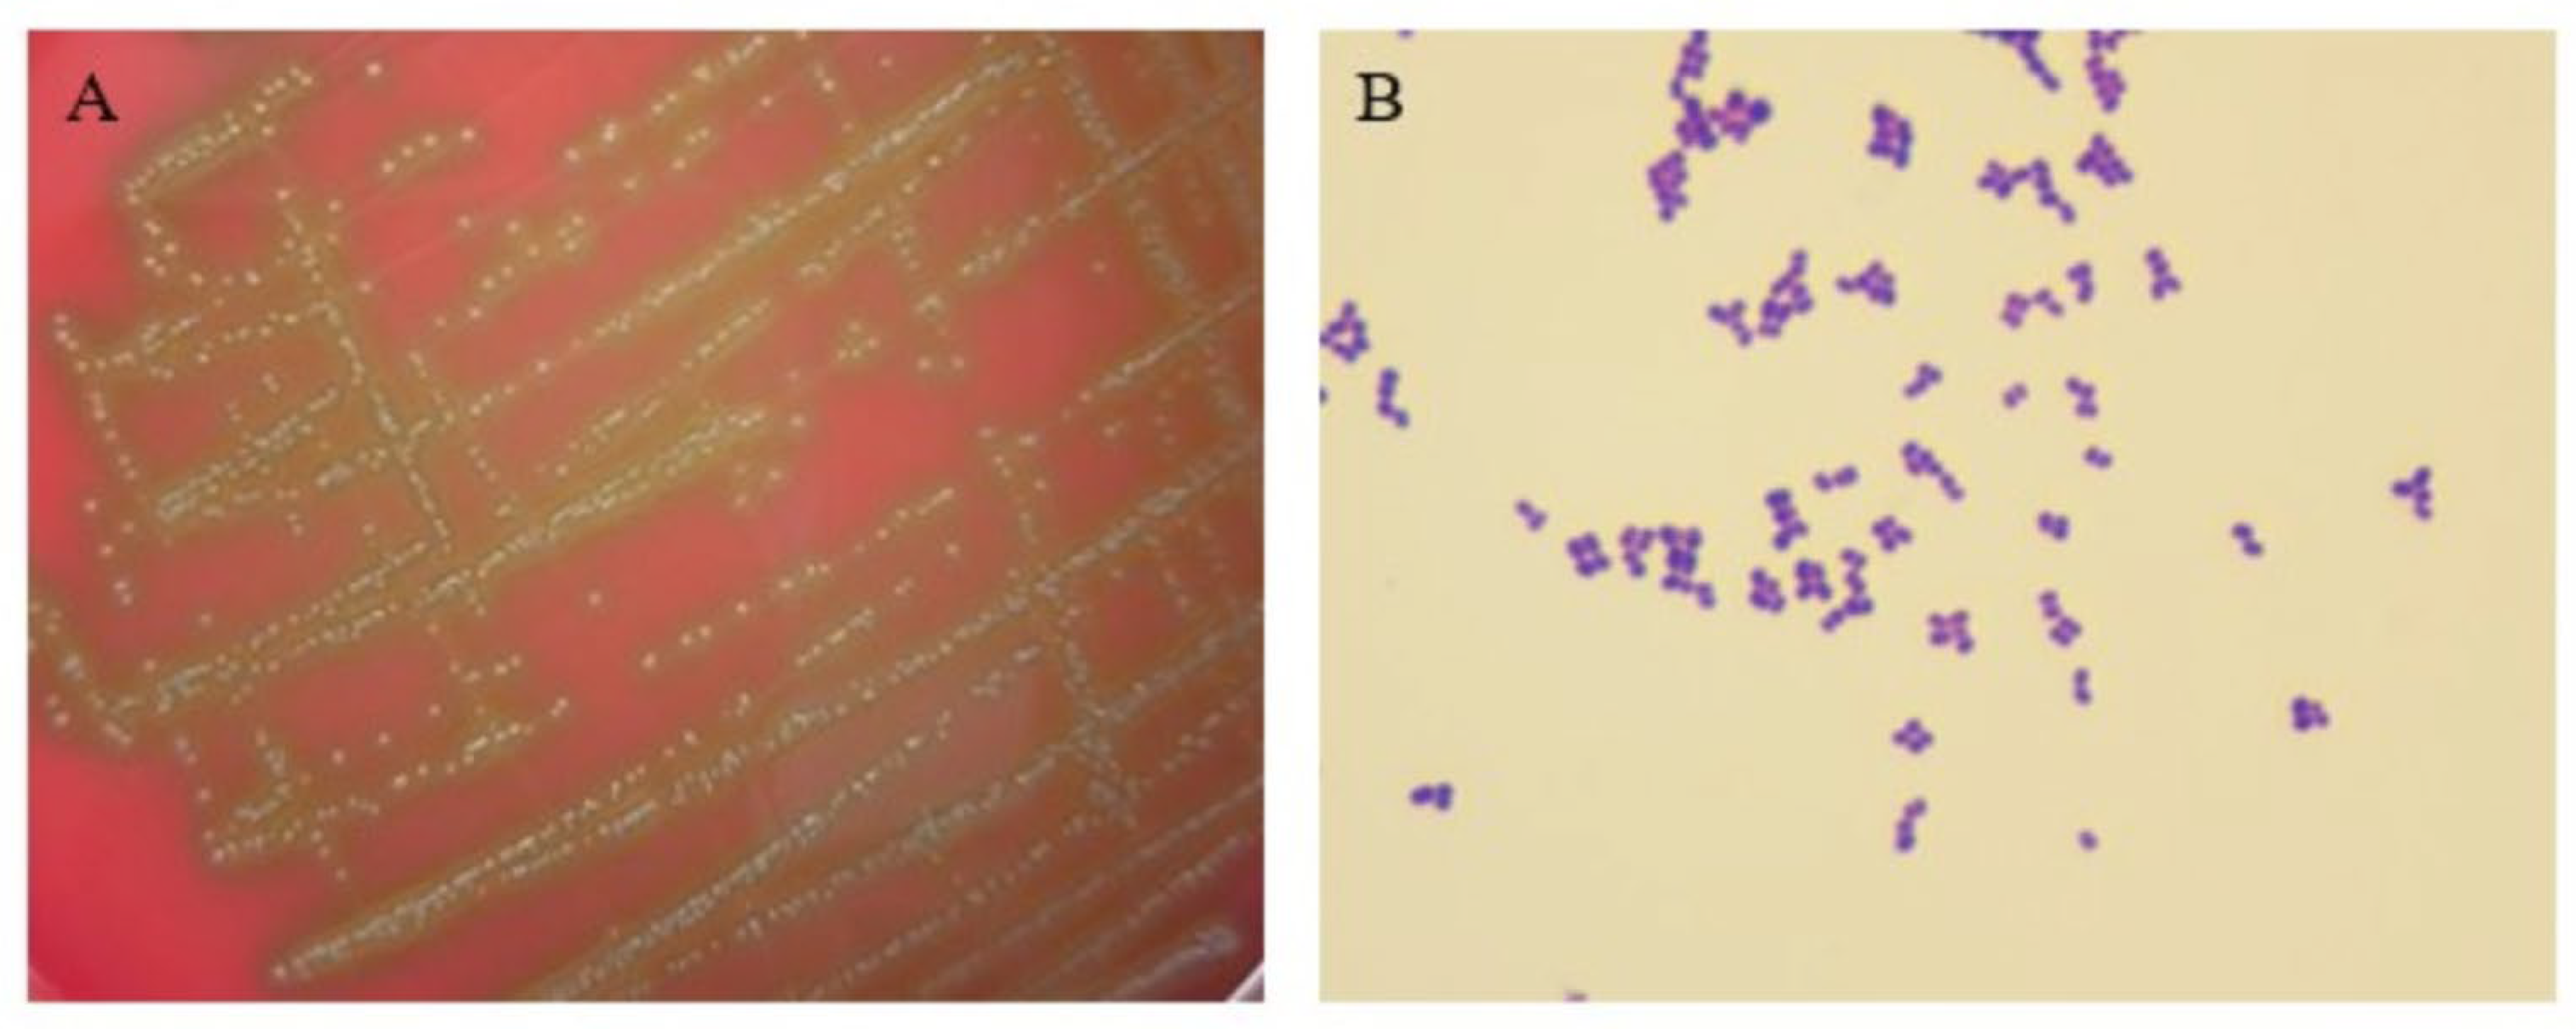
Pathogens 14 00634 g001

Development of a Species-Specific PCR Assay for Aerococcus urinaeequi Using Whole Genome Sequencing
Abstract
1. Introduction
2. Materials and Methods
2.1. Experimental Materials
2.2. Isolation and Morphological Observation
2.3. 16S rRNA Amplification and Sequencing Analysis
2.4. Whole Genome Sequencing and Analysis
2.4.1. Whole Genome Sequencing
2.4.2. Annotation of NR Database
2.4.3. Analysis of ANI
2.5. Establishment of PCR Assay
2.5.1. Screening for Specific Sequence and Designing Primers
2.5.2. Determination of Optimal Annealing Temperature
2.5.3. PCR-Specific Detection
2.5.4. PCR Sensitivity Test
2.5.5. Artificial Infection of Mice and PCR Detection for A. urinaeequi
2.5.6. Detection of A. urinaeequi from Clinical Samples by PCR
3. Results
3.1. Colony and Morphology Observation
3.2. 16S rRNA Sequencing and Analysis Results
3.3. WGS Analysis Results
3.3.1. NR Annotation Results
3.3.2. ANI Analysis Results
3.4. Establishment of the PCR Method
3.4.1. Specific Sequence Screening Results and PCR Establishment
3.4.2. Optimization of Annealing Temperature
3.4.3. Specificity Detection Results
3.4.4. Sensitivity Test Results
3.4.5. PCR Detection for A. urinaeequi from Artificially Infected Mice
3.4.6. PCR Detection of A. urinaeequi from Clinical Samples
4. Discussion
5. Conclusions
Author Contributions
Funding
Institutional Review Board Statement
Informed Consent Statement
Data Availability Statement
Conflicts of Interest
References
- Zhou, W.; Niu, D.; Zhang, Z.; Liu, Y.; Ning, M.; Cao, X.; Zhang, C.; Shen, H. Complete genome sequence of Aerococcus urinaeequi strain AV208. Genome Announc. 2016, 4, e01218-16. [Google Scholar] [CrossRef]
- Williams, R.E.; Hirch, A.; Cowan, S.T. Aerococcus, a new bacterial genus. J. Gen. Microbiol. 1953, 8, 475–480. [Google Scholar] [CrossRef] [PubMed]
- Felis, G.E.; Torriani, S.; Dellaglio, F. Reclassification of Pediococcus urinaeequi (ex Mees 1934) Garvie 1988 as Aerococcus urinaeequi comb. nov. Int. J. Syst. Evol. Microbiol. 2005, 55, 1325–1327. [Google Scholar] [CrossRef] [PubMed]
- Siam, T.; Stephen, T.; Munsiff, S. Case report of Aerococcus urinae tricuspid valve endocarditis, New York, USA. Emerg. Infect. Dis. 2025, 31, 1055–1056. [Google Scholar] [CrossRef] [PubMed]
- Tohno, M.; Kitahara, M.; Matsuyama, S.; Kimura, K.; Ohkuma, M.; Tajima, K. Aerococcus vaginalis sp. nov., isolated from the vaginal mucosa of a beef cow, and emended descriptions of Aerococcus suis, Aerococcus viridans, Aerococcus urinaeequi, Aerococcus urinaehominis, Aerococcus urinae, Aerococcus christensenii and Aerococcus sanguinicola. Int. J. Syst. Evol. Microbiol. 2014, 64, 1229–1236. [Google Scholar] [CrossRef]
- Sun, L.; Qiu, W.; Gao, X.; Cheng, Z.; Huang, K.; Chen, W. Aerococcus agrisoli sp. nov., isolated from paddy soil. Int. J. Syst. Evol. Microbiol. 2023, 73, 6069. [Google Scholar] [CrossRef]
- Choi, B.I.; Ene, A.; Du, J.; Johnson, G.; Putonti, C.; Schouw, C.H.; Dargis, R.; Senneby, E.; Christensen, J.J.; Wolfe, A.J. Taxonomic considerations on Aerococcus urinae with proposal of subdivision into Aerococcus urinae, Aerococcus tenax sp. nov., Aerococcus mictus sp. nov., and Aerococcus loyolae sp. nov. Int. J. Syst. Evol. Microbiol. 2023, 73, 9. [Google Scholar] [CrossRef]
- Bai, L.; Paek, J.; Shin, Y.; Kim, H.; Kim, S.H.; Shin, J.H.; Chang, Y.H. Aerococcus kribbianus sp. nov., a facultatively anaerobic bacterium isolated from pig faeces. Int. J. Syst. Evol. Microbiol. 2024, 74, 2. [Google Scholar] [CrossRef]
- Zabel, M.; Longfellow, L. Aerococcus urinae urinary tract infection in a hospitalised patient: An increasingly common infection. BMJ Case Rep. 2023, 16, e257496. [Google Scholar] [CrossRef]
- Saeed Al-Asad, K.; Mazhar, N.; Srivastava, S.; Quadri, S.; Mitra, S. Aerococcus urinae endocarditis: A case report and literature review. Cureus 2022, 14, e29853. [Google Scholar] [CrossRef]
- Chhibber, A.V.; Muttaiyah, S.; Hill, A.A.; Roberts, S.A. Aerococcus urinae aortitis: A case report. Open Forum Infect. Dis. 2019, 6, 453. [Google Scholar] [CrossRef] [PubMed]
- Varshini, K.; Ganesan, V.; Charles, J. Aerococcus viridans bacteremia: A rare case report from India. Indian J. Crit. Care Med. 2022, 26, 127–128. [Google Scholar] [CrossRef] [PubMed]
- Sun, M.; Gao, J.; Ali, T.; Yu, D.; Zhang, S.; Khan, S.U.; Fanning, S.; Han, B. Characteristics of Aerococcus viridans isolated from bovine subclinical mastitis and its effect on milk SCC, yield, and composition. Trop. Anim. Health Prod. 2017, 49, 843–849. [Google Scholar] [CrossRef] [PubMed]
- Moreno, L.Z.; Matajira, C.E.; Gomes, V.T.; Silva, A.P.; Mesquita, R.E.; Christ, A.P.; Sato, M.I.; Moreno, A.M. Molecular and antibiotic susceptibility characterization of Aerococcus viridans isolated from porcine urinary infection. Vet. Microbiol. 2016, 184, 7–10. [Google Scholar] [CrossRef]
- Stewart, J.E.; Cornick, J.W.; Zwicker, B.M.; Arie, B. Studies on the virulence of Aerococcus viridans var. homari, the causative agent of gaffkemia, a fatal disease of homarid lobsters. Dis. Aquat. Org. 2004, 60, 149–155. [Google Scholar] [CrossRef]
- Yang, Q.; Zhu, Y.; Schwarz, S.; Wang, L.; Liu, W.; Yang, W.; Luan, T.; Liu, S.; Zhang, W. A novel plasmid from Aerococcus urinaeequi of porcine origin co-harboring the tetracycline resistance genes tet(58) and tet(61). Vet. Microbiol. 2021, 257, 109065. [Google Scholar] [CrossRef]
- Heidemann Olsen, R.; Christensen, H.; Kabell, S.; Bisgaard, M. Characterization of prevalent bacterial pathogens associated with pododermatitis in table egg layers. Avian Pathol. 2018, 47, 281–285. [Google Scholar] [CrossRef]
- Devanga Ragupathi, N.K.; Muthuirulandi Sethuvel, D.P.; Inbanathan, F.Y.; Veeraraghavan, B. Accurate differentiation of Escherichia coli and Shigella serogroups: Challenges and strategies. New Microbes New Infect. 2017, 21, 58–62. [Google Scholar] [CrossRef]
- Tu, Q.; Lin, L. Gene content dissimilarity for subclassification of highly similar microbial strains. BMC Genom. 2016, 17, 647. [Google Scholar] [CrossRef]
- Ranjan, R.; Rani, A.; Metwally, A.; McGee, H.S.; Perkins, D.L. Analysis of the microbiome: Advantages of whole genome shotgun versus 16S amplicon sequencing. Biochem. Biophys. Res. Commun. 2016, 469, 967–977. [Google Scholar] [CrossRef]
- Zhou, W.; Gao, S.; Zheng, J.; Zhang, Y.; Zhou, H.; Zhang, Z.; Cao, X.; Shen, H. Identification of an Aerococcus urinaeequi isolate by whole genome sequencing and average nucleotide identity analysis. J. Glob. Antimicrob. Resist. 2022, 29, 353–359. [Google Scholar] [CrossRef] [PubMed]
- Chen, S.; Zhou, Y.; Chen, Y.; Gu, J. fastp: An ultra-fast all-in-one FASTQ preprocessor. Bioinformatics 2018, 34, 884–890. [Google Scholar] [CrossRef] [PubMed]
- Bankevich, A.; Nurk, S.; Antipov, D.; Gurevich, A.A.; Dvorkin, M.; Kulikov, A.S.; Lesin, V.M.; Nikolenko, S.I.; Pham, S.; Prjibelski, A.D.; et al. SPAdes: A new genome assembly algorithm and its applications to single-cell sequencing. J. Comput. Biol. 2012, 19, 455–477. [Google Scholar] [CrossRef]
- Boetzer, M.; Pirovano, W. Toward almost closed genomes with GapFiller. Genome Biol. 2012, 13, 56. [Google Scholar] [CrossRef]
- Massouras, A.; Hens, K.; Gubelmann, C.; Uplekar, S.; Decouttere, F.; Rougemont, J.; Cole, S.T.; Deplancke, B. Primer-initiated sequence synthesis to detect and assemble structural variants. Nat. Methods 2010, 7, 485–486. [Google Scholar] [CrossRef]
- Seemann, T. Prokka: Rapid prokaryotic genome annotation. Bioinformatics 2014, 30, 2068–2069. [Google Scholar] [CrossRef]
- Grant, J.R.; Enns, E.; Marinier, E.; Mandal, A.; Herman, E.K.; Chen, C.Y.; Graham, M.; Van Domselaar, G.; Stothard, P. Proksee: In-depth characterization and visualization of bacterial genomes. Nucleic Acids Res. 2023, 51, 484–492. [Google Scholar] [CrossRef]
- Buchfink, B.; Xie, C.; Huson, D.H. Fast and sensitive protein alignment using DIAMOND. Nat. Methods 2015, 12, 59–60. [Google Scholar] [CrossRef]
- Richter, M.; Rosselló-Móra, R.; Oliver Glöckner, F.; Peplies, J. JSpeciesWS: A web server for prokaryotic species circumscription based on pairwise genome comparison. Bioinformatics 2016, 32, 929–931. [Google Scholar] [CrossRef]
- Chen, C.; Wu, Y.; Li, J.; Wang, X.; Zeng, Z.; Xu, J.; Liu, Y.; Feng, J.; Chen, H.; He, Y.; et al. TBtools-II: A “one for all, all for one” bioinformatics platform for biological big-data mining. Mol. Plant 2023, 16, 1733–1742. [Google Scholar] [CrossRef]
- Katoh, K.; Rozewicki, J.; Yamada, K.D. MAFFT online service: Multiple sequence alignment, interactive sequence choice and visualization. Brief. Bioinform. 2019, 20, 1160–1166. [Google Scholar] [CrossRef] [PubMed]
- Tamura, K.; Stecher, G.; Kumar, S. MEGA11: Molecular evolutionary genetics analysis version 11. Mol. Biol. Evol. 2021, 38, 3022–3027. [Google Scholar] [CrossRef] [PubMed]
- Rasmussen, M. Aerococcus: An increasingly acknowledged human pathogen. Clin. Microbiol. Infect. 2016, 22, 22–27. [Google Scholar] [CrossRef]
- Wang, W.; Chauhan, V.; Luo, Y.; Sharma, S.; Li, C.; Chen, H. Comparing NGS-Based identification of bloodstream infections to traditional culture methods for enhanced ICU care: A comprehensive study. Front. Cell. Infect. Microbiol. 2024, 14, 1454549. [Google Scholar] [CrossRef]
- Cattoir, V.; Kobal, A.; Legrand, P. Aerococcus urinae and Aerococcus sanguinicola, two frequently misidentified uropathogens. Scand. J. Infect. Dis. 2010, 42, 775–780. [Google Scholar] [CrossRef]
- Senneby, E.; Nilson, B.; Petersson, A.C.; Rasmussen, M. Matrix-assisted laser desorption ionization-time of flight mass spectrometry is a sensitive and specific method for identification of aerococci. J. Clin. Microbiol. 2013, 51, 1303–1304. [Google Scholar] [CrossRef]
- Goris, J.; Konstantinidis, K.T.; Klappenbach, J.A.; Coenye, T.; Vandamme, P.; Tiedje, J.M. DNA-DNA hybridization values and their relationship to whole-genome sequence similarities. Int. J. Syst. Evol. Microbiol. 2007, 57, 81–91. [Google Scholar] [CrossRef]
- Rubel, M.H.; Hossain, M.R.; Nath, U.K.; Natarajan, S.; Lee, J.H.; Jung, H.J.; Kim, T.H.; Park, J.I.; Nou, I.S. Development of a PCR test for detection of Xanthomonas campestris pv. raphani. Australas. Plant Pathol. 2019, 48, 179–182. [Google Scholar] [CrossRef]
- Alvandi, H.; Taghavi, S.M.; Khojasteh, M.; Rahimi, T.; Dutrieux, C.; Taghouti, G.; Jacques, M.A.; Portier, P.; Osdaghi, E. Pathovar-specific PCR method for detection and identification of Xanthomonas translucens pv. undulosa. Plant Dis. 2023, 107, 2279–2287. [Google Scholar] [CrossRef]

| Reference Strain | Accession Number | Reference Strain | Accession Number |
|---|---|---|---|
| A. christensenii CCUG28831 | CP014159 | A. christensenii VSI03 | CP118095 |
| A. loyolae UMB0080 | CP126958 | A. loyolae UMB0088 | CP145131 |
| A. loyolae UMB0509 | CP127213 | A. mictus UMB0267 | CP147497 |
| A. mictus UMB1016 | CP145132 | A. sanguinicola CCUG43001 | CP014160 |
| A. tenax UMB0337 | CP142608 | A. tenax UMB7049 | CP145134 |
| A. urinae NBRC 15544 | BCQH00000000 | A. urinae FDAARGOS 911 | CP065662 |
| A. urinae UMB0722 | CP145136 | A. urinaeequi CCUG28094 | CP014162 |
| A. urinaeequi 2020-HN-1 | CP114063 | A. urinaeequi K79-1 | CP116590 |
| A. urinaeequi T43 | CP063065 | A. urinaequi CCUG42038B | CP014163 |
| A. viridans CCUG4311 | CP014164 | A. viridans DSM 20340 | CP118949 |
| A. viridans FDAARGOS 672 | CP046334 | A. urinaeequi USDA-ARS-USMARC-56713 | CP013988 |
| Strain | Host | Country | Year | Accession Number | Genome Size (bp) |
|---|---|---|---|---|---|
| CCUG28094 | Equus caballus | Denmark | 2016 | CP014162 | 2,013,339 |
| USDA-ARS-USMARC-56713 | Bos taurus | America | 2016 | CP013988 | 2,054,328 |
| 2020-HN-1 | Duck | China | 2022 | CP114063 | 2,133,811 |
| T43 | Pig | China | 2020 | CP063065 | 2,055,141 |
| K79-1 | Bos taurus | Switzerland | 2023 | CP116590 | 2,083,683 |
| Animal Species | Sampling Location | Number of Samples | Positive Rate (Positive/Total) | Total Positive Rate (Positive/Total) |
|---|---|---|---|---|
| Geese | Fengyang, Anhui | 62 | 30.6% (19/62) | 36.9% (31/84) |
| Dingyuan, Anhui | 9 | 55.6% (5/9) | ||
| Huaiyuan, Anhui | 13 | 53.8% (7/13) | ||
| Canines | Beijing | 146 | 8.22% (12/146) | 6.96% (16/230) |
| Nantong, Jiangsu | 84 | 4.8% (4/84) | ||
| Felines | Beijing | 92 | 21.7% (20/92) | 21.7% (20/92) |
Disclaimer/Publisher’s Note: The statements, opinions and data contained in all publications are solely those of the individual author(s) and contributor(s) and not of MDPI and/or the editor(s). MDPI and/or the editor(s) disclaim responsibility for any injury to people or property resulting from any ideas, methods, instructions or products referred to in the content. |
© 2025 by the authors. Licensee MDPI, Basel, Switzerland. This article is an open access article distributed under the terms and conditions of the Creative Commons Attribution (CC BY) license (https://creativecommons.org/licenses/by/4.0/).
Share and Cite
Wang, H.; Li, H.; Lu, Z.; Li, W.; Guo, W. Development of a Species-Specific PCR Assay for Aerococcus urinaeequi Using Whole Genome Sequencing. Pathogens 2025, 14, 634. https://doi.org/10.3390/pathogens14070634
Wang H, Li H, Lu Z, Li W, Guo W. Development of a Species-Specific PCR Assay for Aerococcus urinaeequi Using Whole Genome Sequencing. Pathogens. 2025; 14(7):634. https://doi.org/10.3390/pathogens14070634
Chicago/Turabian StyleWang, Hailong, Haixia Li, Zhenxiang Lu, Wenchao Li, and Weina Guo. 2025. "Development of a Species-Specific PCR Assay for Aerococcus urinaeequi Using Whole Genome Sequencing" Pathogens 14, no. 7: 634. https://doi.org/10.3390/pathogens14070634
APA StyleWang, H., Li, H., Lu, Z., Li, W., & Guo, W. (2025). Development of a Species-Specific PCR Assay for Aerococcus urinaeequi Using Whole Genome Sequencing. Pathogens, 14(7), 634. https://doi.org/10.3390/pathogens14070634

